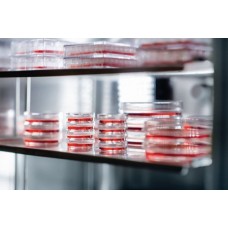
Carbon Dioxide Incubator

Hi Care Lab Solutions products
Edridge-Green Colour Perception Lantern Test Equipment
Edridge-Green Colour Perception Lantern Test EquipmentProduct Details :Minimum Order Quantity: 10 Pi..
₹0
Eddys Hot Plate
Eddys Hot PlateProduct Details :MaterialMild SteelUsage/ApplicationIndustrial OvensShapeRectangularO..
₹0
Dual Gel Electrophoresis System
Dual Gel Electrophoresis SystemProduct Details :MaterialPlasticAutomation TypeSemi-AutomaticBuffer V..
₹0
Double Cone Blender
Double Cone BlenderProduct Details : Model Name/NumberH120Usage/ApplicationMixingMaterialSSShap..
₹0
Double Beam UV-VIS Spectrophotometer
Double Beam UV-VIS SpectrophotometerProduct Details :Wavelength Range190-1100 nmTypePortableApplicat..
₹0
Doctor Centrifuge Machine
Doctor Centrifuge MachineProduct Details :BrandHicare Lab SolutionsSpeed0-3000TypeAnlogModel Name/Nu..
₹0
Disposable Plastic Wares
Disposable Plastic WaresProduct Details :Usage/ApplicationHospital, IVF, Biotech , PathologyBrandFla..
₹0
Digital Pipettes - Lmpp Series
Digital Pipettes - Lmpp SeriesProduct Details :Capacity0-1000 ulChannelsingleUsage/ApplicationallMat..
₹0
Digital Magnetic Stirrer With Hot Plate
Digital Magnetic Stirrer With Hot PlateProduct Details :Model Name/NumberAHMU,AHMU-340 ProMaterialAl..
₹0
Digital Disintegration Test Apparatus
Digital Disintegration Test ApparatusProduct Details :MaterialMild SteelModel Name/NumberHI263Packag..
₹0
Digital COD Digester
Digital COD DigesterProduct Details :Hole Size40 mm - 80 mmDisplayDigitalUsage/ApplicationLaboratory..
₹0
Density Polyethylene (LDPE) 3.0ml, Sterile Individually Wrapped
Density Polyethylene (LDPE) 3.0ml, Sterile Individually WrappedProduct Details :Packaging TypePieceU..
₹0
Density Determination Kit
Density Determination KitProduct Details :Usage/ApplicationLaboratoryBrandWENSARModel Name/NumberWDK..
₹0
CoviPath COVID-19 RT-PCR Kit, ICMR Approved
CoviPath COVID-19 RT-PCR Kit, ICMR ApprovedProduct Details :Number of Reactions(Preps) per Kit200 re..
₹0
Compound Microscope
Compound MicroscopeProduct Details :Magnification50x-600xUsage/ApplicationScience LaboratoryEye Piec..
₹0
CO2 Incubators
CO2 IncubatorsProduct Details :Usage/ApplicationCell CultureCapacity40- 630MaterialMS And SSBrandHi ..
₹0
Ceramic Hotplate Magnetic Stirrer
Ceramic Hotplate Magnetic StirrerProduct Details :Usage/ApplicationLabBrandLabmanMaterialCeramicMode..
₹0
Cell Culture Dishes 60x15 Mm Style Organ Culture (353037)
Cell Culture Dishes 60x15 Mm Style Organ Culture (353037)Product Details :MaterialPolystyreneSize60 ..
₹0
Carbon Dioxide Incubator
Carbon Dioxide IncubatorProduct Details :Dimension760 x 530 x 560 mmUsage/ApplicationLaboratory,Cult..
₹0
Bulk Density Apparatus
Bulk Density ApparatusProduct Details :Frequency50Voltage230Type Of Testing Machines1ColorWhiteWe ar..
₹0